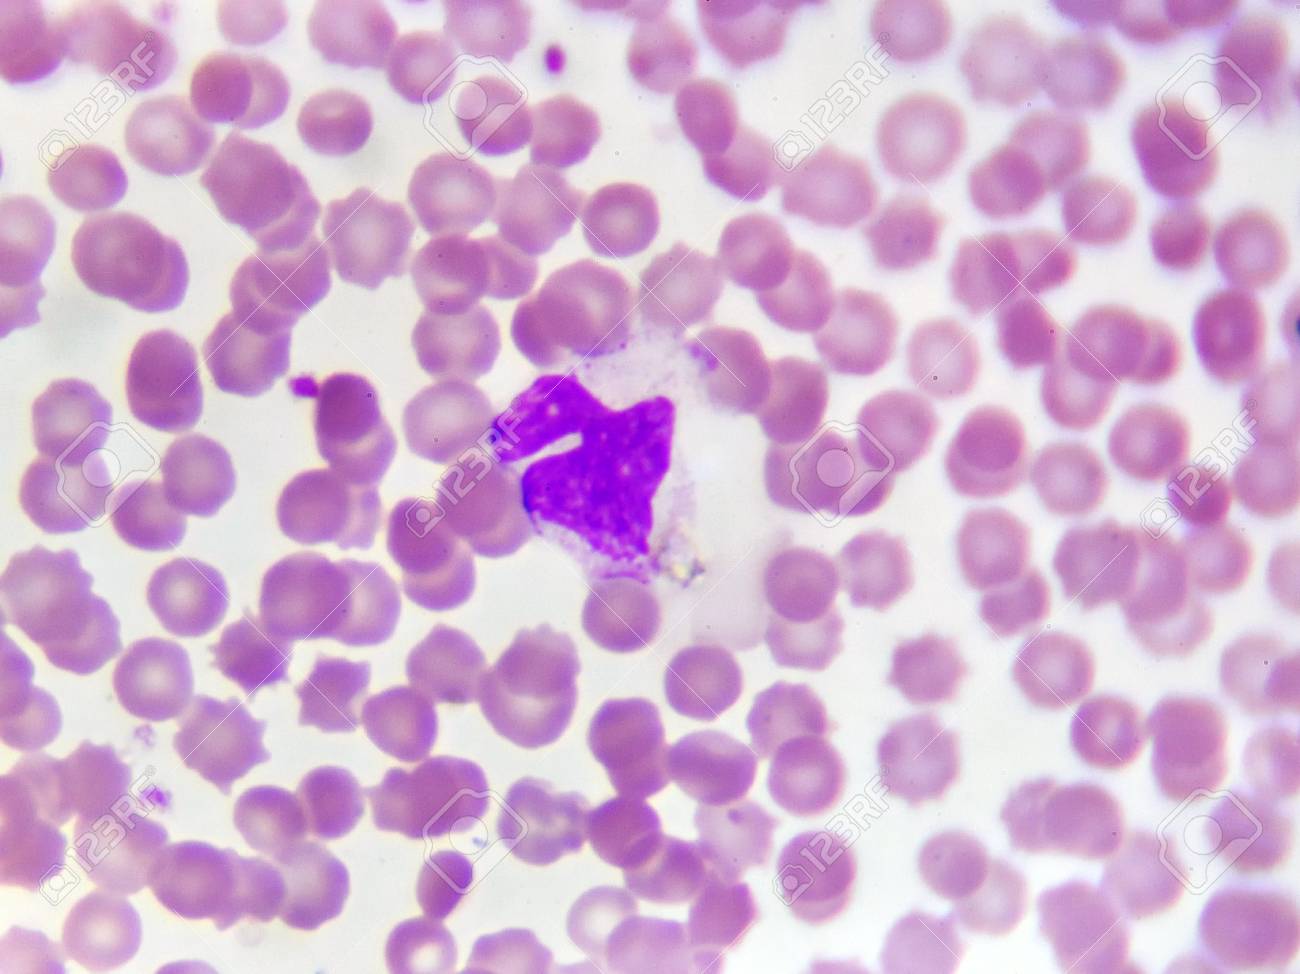
etiam-dictum-ipsum-a-felis

Download
Close
Автор:
id:
Ключевые слова:
abnormal, analyzing, anemia, basophil, blood cells, blood sample, blood smear, blood test, checkup, disease, eosinophil, erythrocyte, examination, health, health care, hematology, hematopoiesis, laboratory, leukemia, leukocyte, lymphocyte, medical, medical exam, medical technology, medical test, microscope, microscopic cells, microscopy, monocyte, neutrophil, pathology, platelet, red blood cell, research, science, test, thalassemia, thrombocyte, white blood cell,





